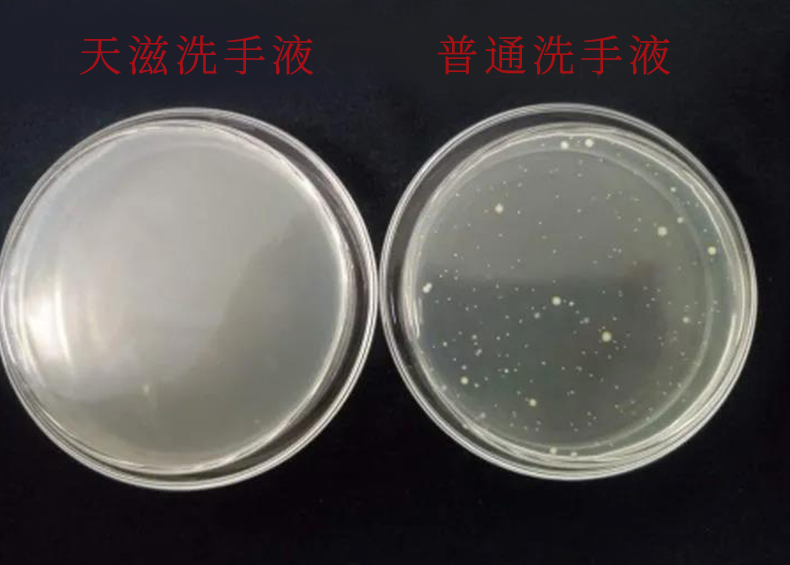
图片
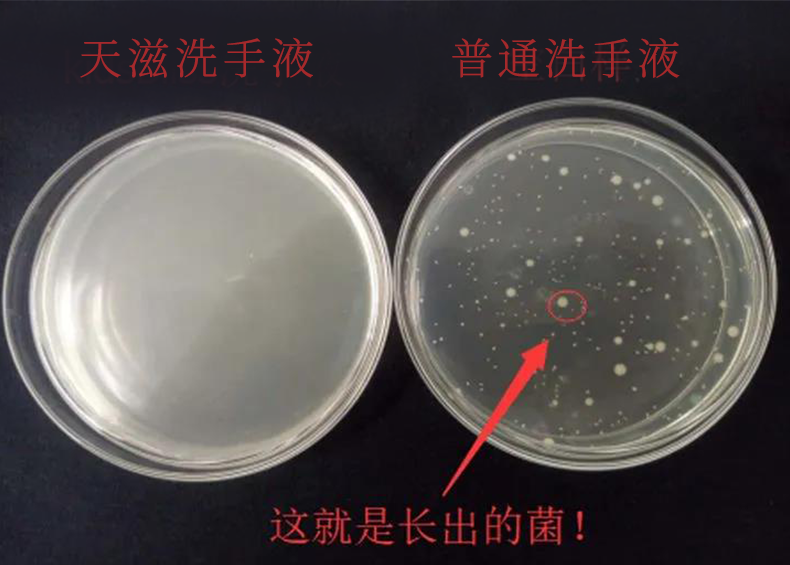
图片

【清仓好价】天滋氨基酸泡沫果香洗手液285ml/花香洗手液285ml (23.3) *2
| 运费: | ¥ 0.00-20.00 |
| 库存: | 86 件 |
商品详情

马来西亚制造,别家都是25元, 蓓蓓这次带给2瓶你只要29.9元,比杂牌都便宜!采用氨基酸作为表活,温和不刺激,洗完后手部不紧绷!小分子魔术泡泡,易过水不残留,泡沫细腻丰富!含有澳洲皇后茶花提取物,天然植物除菌,能去除99.9%的细菌,丰富的泡泡宝宝非常喜欢,小小一瓶全家都可以用,清新的花香和甜甜的果香两种味道都好闻~
保质期到2023年3月9日
英国更有数据显示,疫情期间的含酒精洗手液中毒事件增加了61%。

既然这样
那不用洗手液不就好了!
大多数人都心存侥幸觉得洗手用水冲两下就完事了,事实是,对于细菌病毒,简单的冲洗根本不行!
更不要提,自来水并不真如你所想那样干净!
显微镜下的自来水▼

对这个问题,我们决定重新上架年前卖断货的氨基酸洗手液:

这款洗手液在国内疫情大爆发的时候就推送过给大家,之前只有2000瓶,所以一下子被抢完。
最近后台收到了很多人留言要求重新上架,二话不说,所以马上安排!

为了方便新/老粉选择,我这次照旧先给大家整理推荐理由:

在价格上,依旧做到高性价比!
在全网都紧缺杀菌产品的情况下,品牌方依旧保持产品价格不变,甚至还加大了优惠力度,真的不得不给他们点个赞!
2瓶原价69,
特惠价:29.9!
不能经常出门、目前杀菌基本货量不足,真的要多备一些放在家里随时洗手抗菌才放心。

第一:能有效杀菌!
我们分别在器皿上放了两款不同的洗手液,在加入菌体,测试了大肠杆菌、金黄色葡萄球菌的杀菌情况。
普通洗手液液体直接“变色”甚至开始出现小黄点,而天滋洗手液完好无损!
(▽其他产品长出菌,而洗手液样品没有)
大肠杆菌杀菌情况
金黄色葡萄球菌的杀菌情况则更加明显,不到一个小时,菌体越长越多。
繁殖力惊人。
金黄色葡萄球菌杀菌情况
而且我们还拿去了检测部门做检测,杀菌率高达99%,实实在在。

第二:不添加酒精成分,够安全。
天滋的这款洗手液之所以有那么强的杀菌效果,全靠它的植物成分——澳洲茶树精油。

土著很早就用茶树叶子治疗伤口,毒蛇咬伤也可做为解毒剂,世界大战也曾使用它作为消毒剂。
被称为“天然抗菌剂”,杀菌效果不输酒精杀菌,且安全性更高。

不含酒精成分,平时带出门也不用担心有安全隐患。
看,我们直接用打火机点都能安全通关。

尤其适合小孩使用,要知道宝宝经常舔手,所以必须选无酒精的洗手液。

第三点:杀菌效果够持久。
作为懒癌最怕各一小时就要洗一次手,不仅麻烦,冬天还格外的冷...
这款洗手液让我最喜欢的点就是——用它洗完手像给手上套上一个隐形防护罩,可持续4—5小时。

洗一次能持续抗菌大半天,省事又省心,这种宝藏谁能拒绝啊。


疫情必备项讲完,接着来看洗手液的常规项——清洁力。
天滋依旧没让我失望,一滴下去油直接“躲开”

慕斯设计,轻轻按压就是丰富的泡沫,好玩又省事!

涂抹在手上的时候肉眼可见污渍被轻轻搓掉,滑滑润润超舒服~

而且一冲就干净了,不会有任何的残留。

其次就是它的香味,掏心窝子的说一卷:实在太好闻了。
一个果香一个花香,不浓不呛鼻,每次洗完都忍不住多吸两口~

而且它和我们平时的皂基洗手液不同的是,它采用的是氨基酸,0皂基成分!
以达到清洁的效果,能在清洁的同时保证手部不受伤害

呈现越洗越润的现象:

当然,它也不单单只是水润效果好,温和性能上也是把控得刚刚好。
经过检测呈现弱酸性,超级温和!

而且用完还可以将它“锁”起来,使用的时候对准卡扣就可以啦~


天滋是长兴企业旗下的品牌,长兴企业创立于2003年,拥有国际10万级无尘生产空间,30万级净化车间。

每一款产品的生产都是经过严格审核,保证每一款产品的安全性。

就拿这款洗手液来说,它的其他各项指标也是符合检测标准,所以在安全性能上它可以说是做到了满分!
小孩和老人都能使用,买一瓶全家都能一起用~

除此之外,细查了才知道,原来天滋是澳洲的品牌,产品进入国内也是经过了严格的报关申请的。
果然好的产品都是需要用心做出来的!

它有两个味道,我真的建议大家多囤一些,因为除了疫情期间要使用,日常也是必不可少的。
✔门口放一瓶,进门就消毒
✔厨房放一瓶,做饭更卫生
✔孩子随时用,健康有保证
✔车上放一瓶,路上也干净
✔公司放一瓶,工作不担心
如果需要去医院,那更建议带上一瓶,医院现在病人聚集,更要格外注重清洁。











商品名称:【清仓好价】天滋氨基酸泡沫果香洗手液285ml/花香洗手液285ml (23.3) *2

- 一家卖冠军单品的折扣店 (微信公众号认证)
- 扫描二维码,访问我们的微信店铺
- 随时随地的购物、客服咨询、查询订单和物流...












